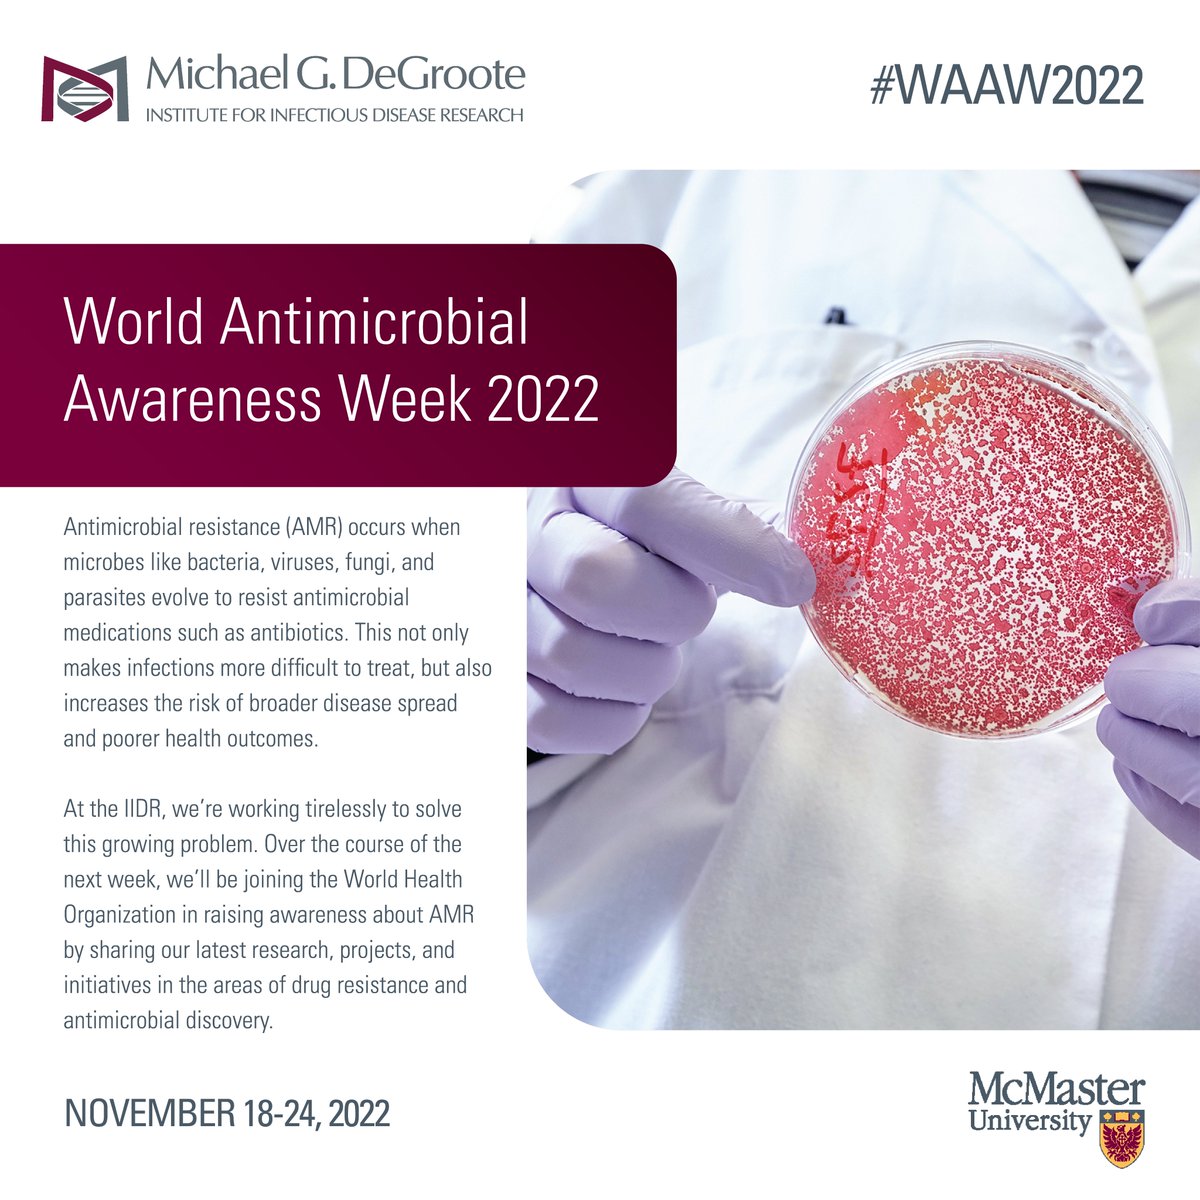
It's World Antimicrobial Awareness Week, a time to bring attention to the growing threat of antimicrobial resistance (#AMR). Over the course of the next week, we'll be sharing the ways in which the IIDR is working to solve this problem. Keep it here for more! #WAAW2022

maya
@microbeswmaya
PhD student @ McMaster University. Antimicrobial Researcher. Aspiring Science Communicator. #diversityinSTEM. She/her🇨🇦🇹🇹
ID: 1293288328050221059
11-08-2020 20:49:09
68 Tweet
164 Takipçi
284 Takip Edilen





Can’t do anything else today OpenAcademics Academic Chatter™ #academictwitter #ECR #phdchat #phdfriend #phdvoice



We are hiring: Black Wellness Counsellor, Job ID 50961 Great partnership between the McMaster Black Student Success Centre and Student Wellness



Between McMaster IIDR and the Global Nexus, McMaster University is truly a hotspot for action against #AMR. Here, some of our experts and trainees explain why this problem is more than just a biomedical issue, and something we all need to work together to solve. #WAAW2022





📣 ComSciConCAN 2025 Results are out! 🎉 It was inspiring to read about all the incredible science communication happening in Canada 🇨🇦 Everyone will receive a decision email from us. Be sure to check your spam folder and add [email protected] to your safe senders list.